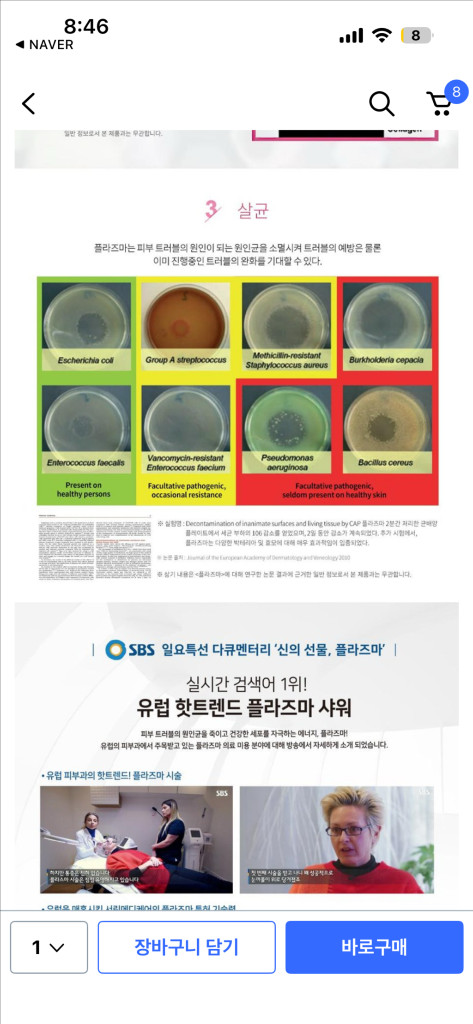
서린메디케어 플라즈마샤워 미용기기(여드름피부필수템) 팝니다 이미지

서린메디케어 플라즈마샤워 기기 팝니다~ ⛔️사기 연락주시는 분들~ 그만 연락주세용^^ 연락하시면 바로 신고 넣어서 계정 정지 시켜드려요~ 라인 유도 좀 그만하세요 ㅠ 플라즈마 미용기기인데 플라즈마가 나와 피부 세포 사이사이 열어주어 ✨제품 흡수력을 높여주고 ✨세포가 일을하게 만들어 재생을 유도하고 ✨살균 항염 효과가 있어서 여드름피부한테 강추드려요! 사용하면 염증이 줄고⬇️ 피부결이 부들부들💦 해지는게 느껴집니다🍀 사용감이 있는 점 참고해주세요!! 이 제품으로 염증 많이 좋아지고 결도 좋아져서 주변사람들한테 피부 좋아졌단 말 많이 들었습니다 ㅎㅎ 강추드려요👍🏻🩷